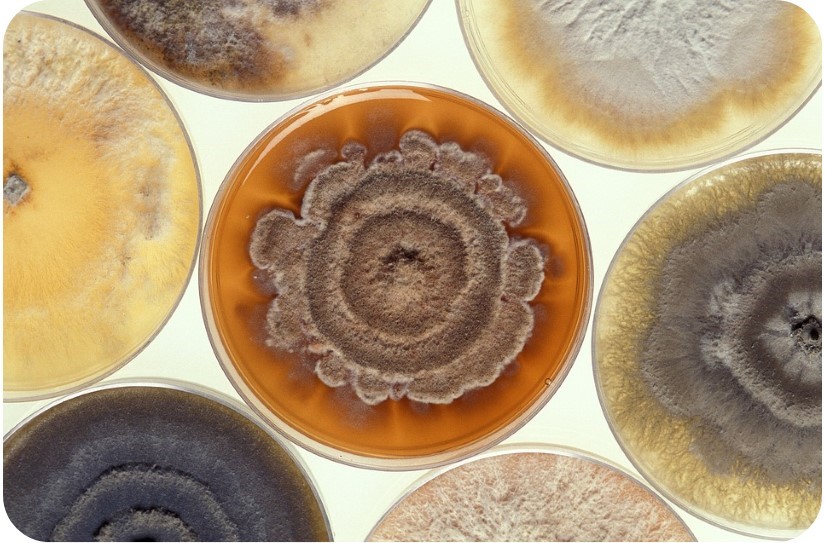

Symptômes irritatifs, conjonctivites,
atteinte des voies respiratoires supérieures et inférieures, épistaxis,
aspergillose broncho-pulmonaire allergique, sinusite fongique allergique,
troubles dermatologiques, .... les symptômes et pathologies liés à une exposition
à des moisissures sont nombreux et variés. Parmi les sources d'exposition
aux polluants intérieurs, les moisissures représentent en effet une
source fréquente et non négligeable.
Au travers de l'analyse de cas clinique, exercices et mises en situation, ce module vous invite à identifier les moisissures visibles, mais également cachées, dans l'environnement intérieur, à comprendre les conditions de leur développement et les symptômes et pathologies associés. Le module propose ensuite des pistes de remédiation, après s'être interrogé sur le rôle du médecin et des outils complémentaires d'aide au diagnostic mis à sa disposition par les services publiques.
